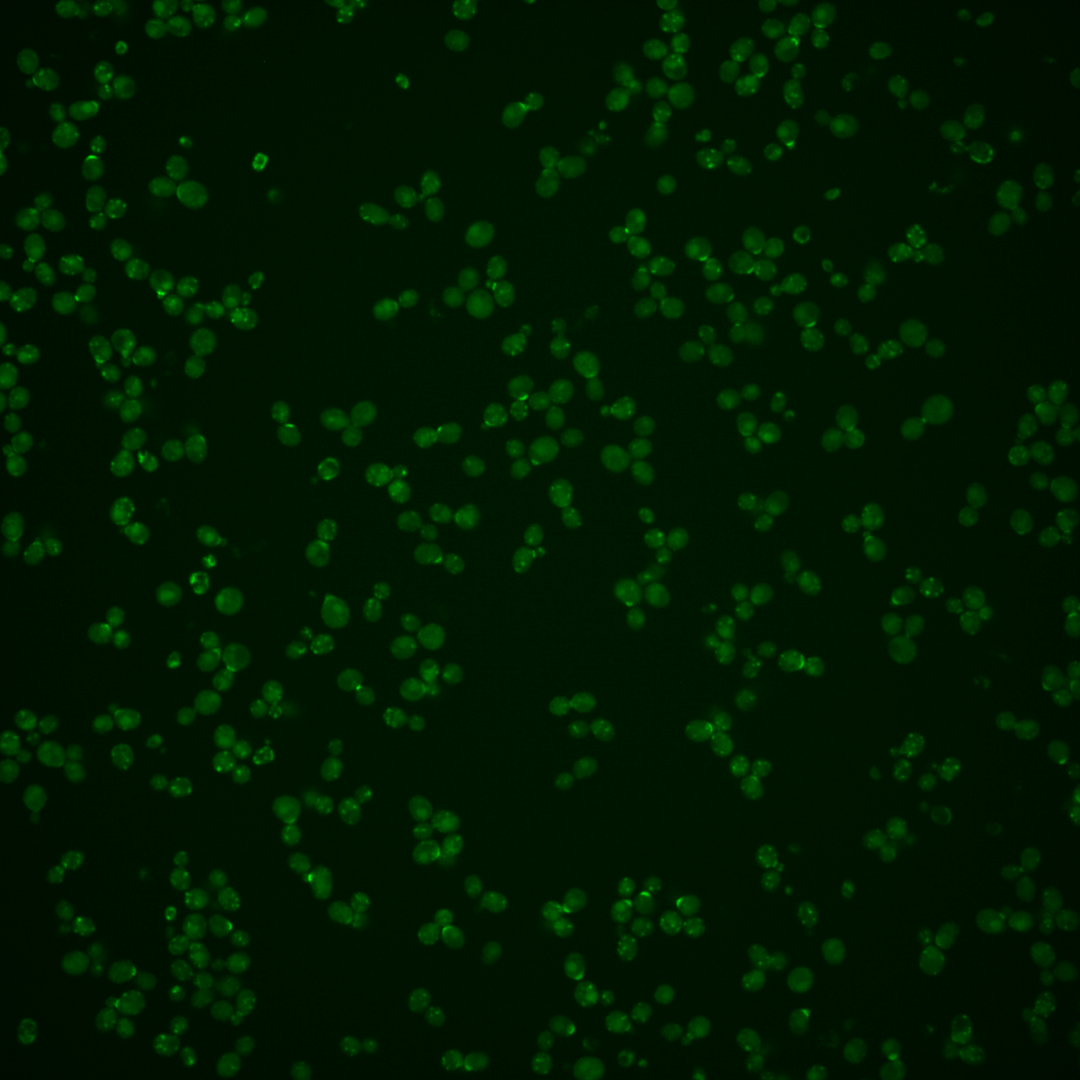
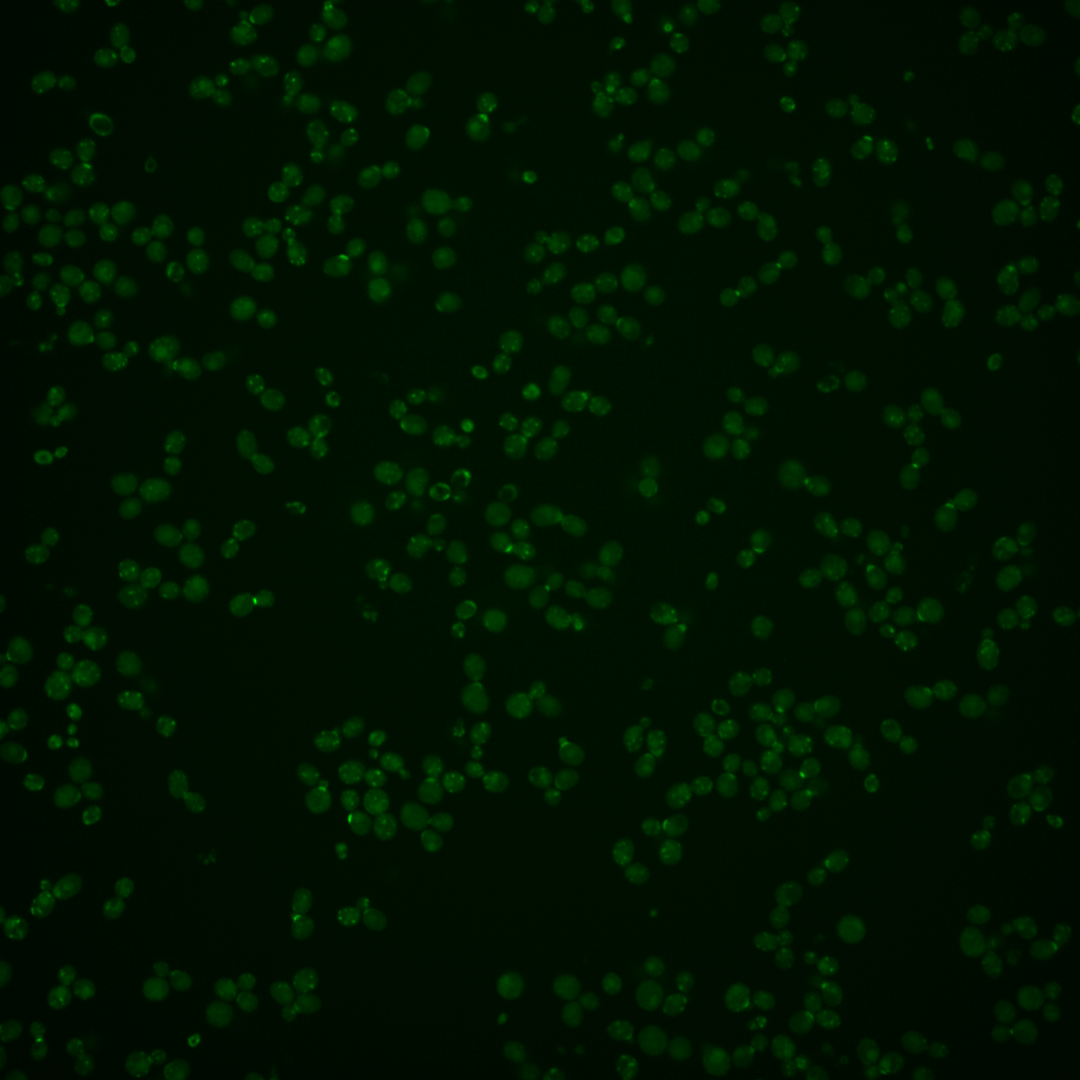
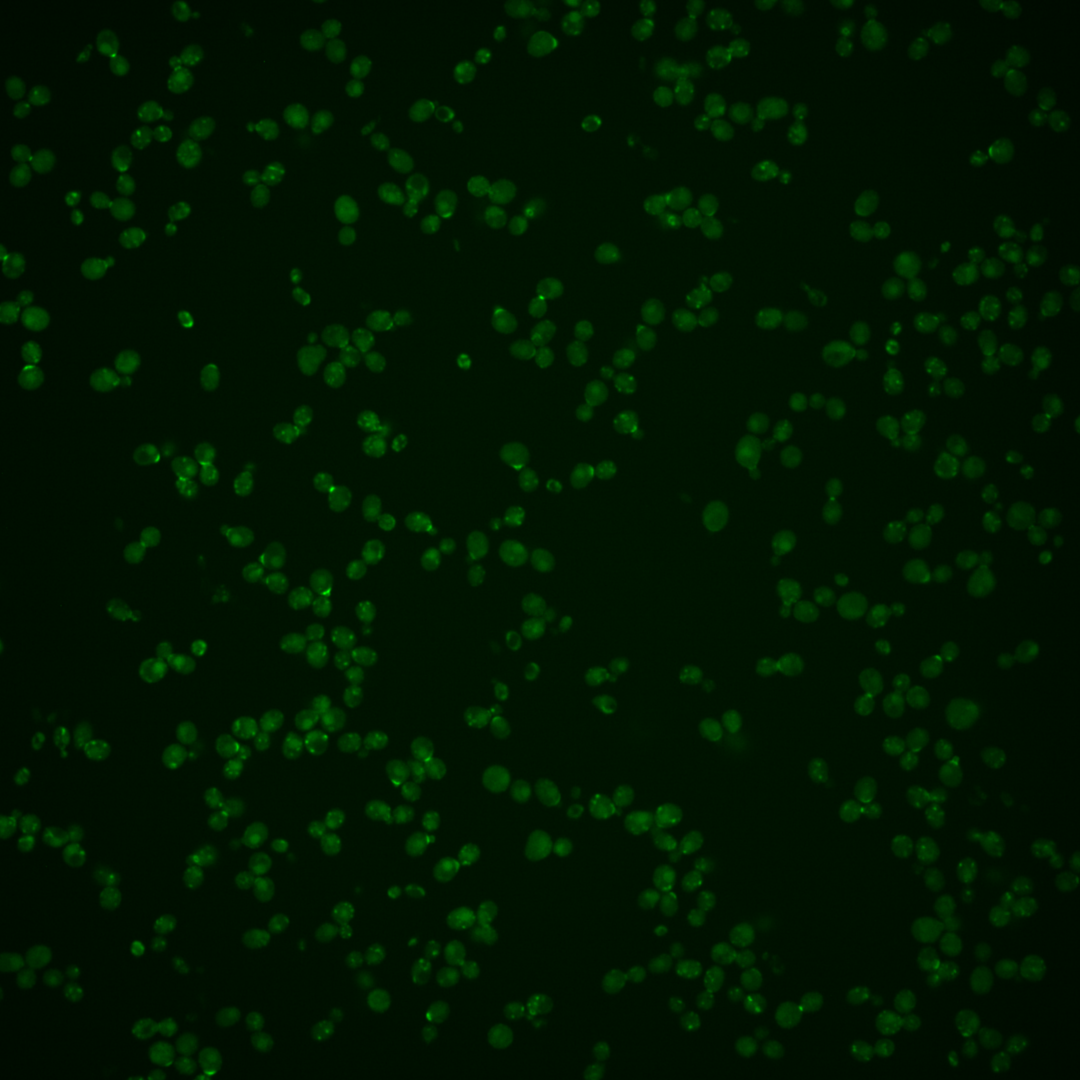

| Standard name | |
|---|---|
| Human Ortholog | |
| Description | Chitin synthase III; catalyzes the transfer of N-acetylglucosamine (GlcNAc) to chitin; required for synthesis of the majority of cell wall chitin, the chitin ring during bud emergence, and spore wall chitosan; contains overlapping di-leucine and di-acidic signals that mediate, respectively, intracellular trafficking by AP-1 and trafficking to plasma membrane by exomer complex; requires AP-3 complex for its intracellular retention |
Micrographs




















































































Sub-cellular Localization
Yeast GFP Assignment
Protein Abundance
Localization Change
External localization resources
| ensLOC | DeepLoc | |||||||||||||||||||||||
|---|---|---|---|---|---|---|---|---|---|---|---|---|---|---|---|---|---|---|---|---|---|---|---|---|
| Localization | WT1 | WT2 | WT3 | RAP60 | RAP140 | RAP220 | RAP300 | RAP380 | RAP460 | RAP540 | RAP620 | RAP700 | HU80 | HU120 | HU160 | rpd3Δ_1 | rpd3Δ_2 | rpd3Δ_3 | WT1 | WT2 | WT3 | AF100 | AF140 | AF180 |
| Cortical Patches | 29 | 11 | 14 | 15 | 6 | 11 | 5 | 2 | 4 | 4 | 5 | 4 | 23 | 25 | 23 | 23 | 16 | 13 | 28 | 7 | 25 | 32 | 47 | 55 |
| Bud | 5 | 6 | 3 | 4 | 8 | 4 | 12 | 18 | 12 | 9 | 11 | 23 | 6 | 6 | 2 | 9 | 6 | 2 | 22 | 10 | 8 | 56 | 35 | 24 |
| Bud Neck | 0 | 0 | 0 | 0 | 0 | 0 | 0 | 0 | 0 | 0 | 0 | 0 | 0 | 0 | 1 | 0 | 1 | 0 | 28 | 11 | 17 | 42 | 36 | 20 |
| Bud Site | 7 | 2 | 9 | 6 | 6 | 7 | 2 | 0 | 1 | 1 | 2 | 7 | 0 | 0 | 1 | 3 | 5 | 1 | – | – | – | – | – | – |
| Cell Periphery | 1 | 2 | 3 | 7 | 2 | 0 | 3 | 2 | 3 | 1 | 1 | 1 | 2 | 2 | 7 | 2 | 0 | 1 | 0 | 0 | 0 | 4 | 5 | 5 |
| Cytoplasm | 106 | 44 | 55 | 125 | 127 | 167 | 219 | 306 | 208 | 228 | 174 | 239 | 89 | 89 | 110 | 81 | 26 | 33 | 2 | 3 | 1 | 4 | 3 | 5 |
| Endoplasmic Reticulum | 30 | 19 | 19 | 15 | 15 | 16 | 6 | 7 | 9 | 1 | 4 | 3 | 22 | 19 | 27 | 7 | 5 | 9 | 40 | 7 | 17 | 19 | 68 | 90 |
| Endosome | 65 | 8 | 43 | 24 | 53 | 33 | 49 | 43 | 19 | 20 | 8 | 20 | 14 | 15 | 11 | 41 | 27 | 34 | 74 | 26 | 37 | 3 | 6 | 7 |
| Golgi | 25 | 7 | 12 | 2 | 1 | 1 | 0 | 0 | 0 | 0 | 1 | 0 | 9 | 10 | 5 | 17 | 16 | 26 | 64 | 15 | 42 | 1 | 10 | 7 |
| Mitochondria | 19 | 13 | 24 | 6 | 5 | 13 | 17 | 23 | 22 | 41 | 36 | 37 | 5 | 5 | 1 | 29 | 18 | 15 | 9 | 4 | 6 | 15 | 20 | 21 |
| Nucleus | 11 | 1 | 1 | 1 | 3 | 9 | 23 | 29 | 10 | 7 | 3 | 4 | 2 | 2 | 2 | 9 | 1 | 2 | 0 | 0 | 0 | 1 | 0 | 0 |
| Nuclear Periphery | 0 | 1 | 1 | 0 | 0 | 0 | 0 | 1 | 1 | 4 | 1 | 0 | 0 | 0 | 0 | 1 | 0 | 0 | 2 | 0 | 1 | 1 | 2 | 3 |
| Nucleolus | 3 | 3 | 2 | 2 | 5 | 5 | 5 | 19 | 1 | 2 | 1 | 5 | 0 | 0 | 0 | 0 | 1 | 2 | 1 | 0 | 0 | 0 | 0 | 0 |
| Peroxisomes | 11 | 3 | 15 | 2 | 9 | 4 | 3 | 2 | 2 | 0 | 1 | 2 | 0 | 2 | 0 | 3 | 6 | 3 | 3 | 1 | 4 | 0 | 0 | 0 |
| SpindlePole | 10 | 1 | 11 | 4 | 10 | 2 | 5 | 4 | 2 | 2 | 2 | 3 | 9 | 8 | 8 | 19 | 14 | 4 | 1 | 0 | 0 | 0 | 0 | 0 |
| Vac/Vac Membrane | 264 | 29 | 76 | 36 | 138 | 127 | 190 | 239 | 114 | 144 | 53 | 75 | 8 | 8 | 8 | 72 | 47 | 55 | 346 | 85 | 136 | 93 | 190 | 197 |
| Unique Cell Count | 482 | 127 | 227 | 217 | 324 | 326 | 447 | 597 | 336 | 380 | 258 | 357 | 169 | 170 | 188 | 240 | 140 | 159 | 628 | 175 | 304 | 279 | 432 | 444 |
| Labelled Cell Count | 586 | 150 | 288 | 249 | 388 | 399 | 539 | 695 | 408 | 464 | 303 | 423 | 189 | 191 | 206 | 316 | 189 | 200 | 628 | 175 | 304 | 279 | 432 | 444 |
Yeast GFP Assignment
Protein Abundance
| Screen | WT1 | WT2 | WT3 | RAP60 | RAP140 | RAP220 | RAP300 | RAP380 | RAP460 | RAP540 | RAP620 | RAP700 | HU80 | HU120 | HU160 | rpd3Δ_1 | rpd3Δ_2 | rpd3Δ_3 | AF100 | AF140 | AF180 |
|---|---|---|---|---|---|---|---|---|---|---|---|---|---|---|---|---|---|---|---|---|---|
| Mean Cell GFP Intensity (1e-4) | 8.9 | 8.5 | 8.3 | 8.0 | 8.5 | 7.5 | 7.2 | 7.3 | 7.1 | 6.5 | 6.6 | 6.3 | 7.4 | 7.4 | 7.1 | 6.7 | 7.6 | 9.3 | 9.9 | 10.8 | 11.7 |
| Std Deviation (1e-4) | 1.4 | 1.5 | 1.7 | 1.9 | 1.8 | 1.6 | 1.5 | 1.8 | 1.6 | 1.4 | 1.6 | 1.3 | 1.1 | 1.1 | 1.1 | 1.1 | 1.6 | 2.2 | 2.0 | 2.4 | 2.5 |
| Intensity Change (Log2) | – | – | – | -0.06 | 0.03 | -0.14 | -0.2 | -0.19 | -0.24 | -0.36 | -0.34 | -0.4 | -0.17 | -0.17 | -0.22 | -0.31 | -0.13 | 0.16 | 0.25 | 0.37 | 0.49 |
Localization Change
| Localization | RAP60 | RAP140 | RAP220 | RAP300 | RAP380 | RAP460 | RAP540 | RAP620 | RAP700 | HU80 | HU120 | HU160 | rpd3Δ_1 | rpd3Δ_2 | rpd3Δ_3 |
|---|---|---|---|---|---|---|---|---|---|---|---|---|---|---|---|
| Cortical Patches | 0.3 | -2.7 | -1.6 | -3.7 | 0 | -3.3 | -3.6 | -2.4 | -3.4 | 2.5 | 2.8 | 2.2 | 1.4 | 1.8 | 0.8 |
| Bud | 0 | 0 | 0 | 1.1 | 1.4 | 1.6 | 0 | 1.9 | 2.9 | 0 | 0 | 0 | 1.7 | 0 | 0 |
| Bud Neck | 0 | 0 | 0 | 0 | 0 | 0 | 0 | 0 | 0 | 0 | 0 | 0 | 0 | 0 | 0 |
| Bud Site | -0.7 | -1.5 | -1.3 | 0 | 0 | 0 | 0 | -2.4 | -1.4 | 0 | 0 | 0 | -1.9 | -0.2 | 0 |
| Cell Periphery | 0 | 0 | 0 | 0 | 0 | 0 | 0 | 0 | 0 | 0 | 0 | 0 | 0 | 0 | 0 |
| Cytoplasm | 7.2 | 3.7 | 6.4 | 6.2 | 7.0 | 8.8 | 8.5 | 9.5 | 10.1 | 5.8 | 5.8 | 7.1 | 2.3 | -1.3 | -0.8 |
| Endoplasmic Reticulum | -0.6 | -1.8 | -1.6 | -4.6 | -5.3 | -3.0 | -5.4 | -3.5 | -4.7 | 1.5 | 0.9 | 1.9 | -2.6 | -1.8 | -1.0 |
| Endosome | -2.3 | -0.8 | -3.0 | -2.9 | -4.9 | -4.9 | -5.3 | -5.7 | -5.1 | -3.0 | -2.8 | -3.9 | -0.5 | 0.1 | 0.6 |
| Golgi | -2.6 | -3.8 | -3.8 | 0 | 0 | 0 | 0 | -3.3 | 0 | 0 | 0.3 | -1.3 | 0.8 | 2.2 | 3.6 |
| Mitochondria | -3.3 | -4.7 | -3.0 | -3.5 | -3.7 | -1.7 | 0.1 | 1.1 | -0.1 | -2.9 | -2.9 | -4.3 | 0.5 | 0.7 | -0.4 |
| Nucleus | 0 | 0 | 0 | 3.1 | 3.0 | 0 | 0 | 0 | 0 | 0 | 0 | 0 | 0 | 0 | 0 |
| Nuclear Periphery | 0 | 0 | 0 | 0 | 0 | 0 | 0 | 0 | 0 | 0 | 0 | 0 | 0 | 0 | 0 |
| Nucleolus | 0 | 0 | 0 | 0 | 1.9 | 0 | 0 | 0 | 0 | 0 | 0 | 0 | 0 | 0 | 0 |
| Peroxisomes | -3.1 | -2.2 | -3.4 | -4.5 | 0 | -4.1 | -5.1 | -3.8 | -4.2 | -3.4 | -2.6 | -3.6 | -3.0 | -0.9 | -2.2 |
| SpindlePole | -1.8 | -1.1 | -3.2 | -3.0 | 0 | -3.3 | 0 | -2.8 | -3.1 | 0.2 | -0.1 | -0.3 | 1.4 | 1.9 | -1.2 |
| Vacuole | -4.1 | 2.2 | 1.3 | 2.3 | 1.7 | 0.1 | 1.1 | -3.2 | -3.4 | -6.9 | -6.9 | -7.4 | -0.8 | 0 | 0.2 |
External localization resources
Images






























Protein Concentration and Protein Localization Data
| R1 | R2 | R3 | ||||||||||||||||
|---|---|---|---|---|---|---|---|---|---|---|---|---|---|---|---|---|---|---|
| G1 Pre-START | G1 Post-START | S/G2 | Metaphase | Anaphase | Telophase | G1 Pre-START | G1 Post-START | S/G2 | Metaphase | Anaphase | Telophase | G1 Pre-START | G1 Post-START | S/G2 | Metaphase | Anaphase | Telophase | |
| Concentration | 3.4283 | 6.0396 | 5.146 | 4.7011 | 4.0667 | 4.8833 | 5.4419 | 6.5388 | 6.8275 | 5.6053 | 6.0519 | 6.5886 | 5.99 | 6.9577 | 6.5664 | 6.7892 | 7.1822 | 6.4801 |
| Actin | 0.0828 | 0.0245 | 0.068 | 0.0057 | 0.0161 | 0.0512 | 0.0929 | 0.0506 | 0.0507 | 0.0014 | 0.0018 | 0.0768 | 0.1566 | 0.0056 | 0.0924 | 0.0064 | 0.0007 | 0.0329 |
| Bud | 0.0045 | 0.0041 | 0.0036 | 0.0017 | 0.0007 | 0.0016 | 0.0037 | 0.0106 | 0.0031 | 0.0006 | 0.002 | 0.0019 | 0.0015 | 0.0023 | 0.0039 | 0.0003 | 0.0003 | 0.0013 |
| Bud Neck | 0.0284 | 0.0205 | 0.073 | 0.0106 | 0.0254 | 0.4361 | 0.0208 | 0.0291 | 0.0684 | 0.0016 | 0.0312 | 0.3534 | 0.0026 | 0.043 | 0.0607 | 0.0011 | 0.0007 | 0.3544 |
| Bud Periphery | 0.0072 | 0.0043 | 0.0064 | 0.0199 | 0.0008 | 0.0027 | 0.0054 | 0.0123 | 0.0037 | 0.0008 | 0.0017 | 0.0037 | 0.0012 | 0.0031 | 0.0035 | 0.0003 | 0.0002 | 0.0027 |
| Bud Site | 0.1169 | 0.2757 | 0.1023 | 0.0012 | 0.0027 | 0.0042 | 0.0957 | 0.3963 | 0.092 | 0.0011 | 0.0073 | 0.0041 | 0.0032 | 0.2127 | 0.0807 | 0.0004 | 0.0006 | 0.0044 |
| Cell Periphery | 0.0115 | 0.0048 | 0.0044 | 0.003 | 0.0005 | 0.0011 | 0.0134 | 0.0059 | 0.004 | 0.0002 | 0.0004 | 0.0022 | 0.0135 | 0.0122 | 0.0012 | 0.0001 | 0 | 0.0033 |
| Cytoplasm | 0.0967 | 0.0401 | 0.0167 | 0.0049 | 0.0083 | 0.0555 | 0.0816 | 0.0527 | 0.0347 | 0.0093 | 0.02 | 0.0553 | 0.0497 | 0.1669 | 0.0097 | 0.0021 | 0.0107 | 0.0607 |
| Cytoplasmic Foci | 0.1072 | 0.1073 | 0.103 | 0.1025 | 0.1127 | 0.0865 | 0.1363 | 0.0654 | 0.1173 | 0.138 | 0.1684 | 0.0886 | 0.1114 | 0.1277 | 0.1563 | 0.1015 | 0.1327 | 0.0984 |
| Eisosomes | 0.0005 | 0.0001 | 0.0003 | 0 | 0.0001 | 0.0005 | 0.0002 | 0.0001 | 0.0002 | 0 | 0 | 0.0002 | 0.0002 | 0.0001 | 0.0002 | 0.0001 | 0 | 0.0002 |
| Endoplasmic Reticulum | 0.0109 | 0.0042 | 0.0027 | 0.0012 | 0.0056 | 0.0058 | 0.0069 | 0.0018 | 0.0018 | 0.0015 | 0.0017 | 0.0066 | 0.0295 | 0.0086 | 0.0012 | 0.0013 | 0.0015 | 0.0139 |
| Endosome | 0.2163 | 0.2164 | 0.239 | 0.4194 | 0.3799 | 0.1525 | 0.2743 | 0.1446 | 0.2808 | 0.4659 | 0.4368 | 0.1694 | 0.2111 | 0.1072 | 0.2361 | 0.3249 | 0.4571 | 0.1387 |
| Golgi | 0.1167 | 0.1488 | 0.2516 | 0.3372 | 0.3188 | 0.1384 | 0.1117 | 0.1315 | 0.2162 | 0.2863 | 0.259 | 0.1375 | 0.1207 | 0.1319 | 0.2848 | 0.4667 | 0.3632 | 0.1807 |
| Lipid Particles | 0.0375 | 0.0355 | 0.0198 | 0.0258 | 0.0217 | 0.016 | 0.0647 | 0.0074 | 0.0259 | 0.0379 | 0.0249 | 0.0158 | 0.1802 | 0.0263 | 0.0147 | 0.0195 | 0.0096 | 0.0389 |
| Mitochondria | 0.0259 | 0.0058 | 0.0339 | 0.0075 | 0.0126 | 0.009 | 0.0043 | 0.0092 | 0.0204 | 0.0147 | 0.0095 | 0.0208 | 0.0021 | 0.0202 | 0.0112 | 0.058 | 0.0041 | 0.0123 |
| None | 0.0075 | 0.0107 | 0.0009 | 0.0001 | 0.0021 | 0.0076 | 0.0063 | 0.0017 | 0.0034 | 0.0001 | 0.0007 | 0.0133 | 0.0157 | 0.0135 | 0.0003 | 0.0001 | 0.0001 | 0.0006 |
| Nuclear Periphery | 0.0068 | 0.0027 | 0.0017 | 0.0006 | 0.0092 | 0.0027 | 0.002 | 0.0006 | 0.0013 | 0.0004 | 0.0005 | 0.0013 | 0.0416 | 0.0018 | 0.0002 | 0.0002 | 0.0004 | 0.0006 |
| Nucleolus | 0.0018 | 0.0014 | 0.0009 | 0.0003 | 0.0005 | 0.0007 | 0.0005 | 0.0011 | 0.0019 | 0.0001 | 0.0003 | 0.0005 | 0.001 | 0.0014 | 0.0003 | 0.0001 | 0 | 0.0004 |
| Nucleus | 0.0075 | 0.0019 | 0.001 | 0.0004 | 0.0027 | 0.0011 | 0.0009 | 0.0014 | 0.0017 | 0.0002 | 0.0004 | 0.0011 | 0.0137 | 0.0015 | 0.0004 | 0.0001 | 0.0001 | 0.0006 |
| Peroxisomes | 0.04 | 0.0187 | 0.0241 | 0.0032 | 0.0247 | 0.0104 | 0.019 | 0.012 | 0.034 | 0.0173 | 0.0177 | 0.0224 | 0.0037 | 0.0131 | 0.0314 | 0.0105 | 0.0044 | 0.0266 |
| Punctate Nuclear | 0.0131 | 0.0007 | 0.0014 | 0.0008 | 0.0116 | 0.0019 | 0.0015 | 0.0018 | 0.0021 | 0.0003 | 0.0005 | 0.0042 | 0.0145 | 0.0017 | 0.0007 | 0.0002 | 0.0001 | 0.0005 |
| Vacuole | 0.055 | 0.0661 | 0.0374 | 0.0495 | 0.0383 | 0.0117 | 0.0542 | 0.0589 | 0.0325 | 0.0167 | 0.0115 | 0.0181 | 0.0234 | 0.0969 | 0.0082 | 0.0038 | 0.0092 | 0.0256 |
| Vacuole Periphery | 0.0053 | 0.0057 | 0.0078 | 0.0044 | 0.005 | 0.0028 | 0.0036 | 0.0051 | 0.0039 | 0.0054 | 0.0036 | 0.0028 | 0.0029 | 0.0023 | 0.0018 | 0.0024 | 0.0041 | 0.0023 |
Sequencing Data
| R1 | R2 | |||||||||
|---|---|---|---|---|---|---|---|---|---|---|
| G1 Post-START | S/G2 | Metaphase | Anaphase | Telophase | G1 Post-START | S/G2 | Metaphase | Anaphase | Telophase | |
| Gene Expression | 68.2925 | 35.2479 | 31.805 | 41.2763 | 66.6637 | 61.1612 | 40.5573 | 29.5383 | 36.3119 | 64.5321 |
| Translational Efficiency | 0.6925 | 0.7054 | 0.6293 | 0.6086 | 0.5361 | 0.7201 | 0.5299 | 0.5722 | 0.5176 | 0.5187 |
Hit Data
| Dataset | Hit |
|---|---|
| Protein Concentration | ✘ |
| Protein Localization | ✔ |
| Gene Expression | ✔ |
| Translational Efficiency | ✘ |
Endocytosis
| Temp | Actin Patch (Sac6-tdTomato) | Cortical Patch (Sla1-GFP) | Late Endosome (Snf7-GFP) | Vacuole (Vph1-GFP) |
|---|---|---|---|---|
| 37℃ | ||||
| RT |
Cell Cycle Omics
CYCLoPs (Chs3-GFP)
| Gene / Allele | Actin Patch (Sac6-tdTomato) | Cortical Patch (Sla1-GFP) | Late Endosome (Snf7-GFP) | Vacuole (Sac6-tdTomato) |
|---|
| Gene | Images |
|---|
| Gene | Images |
|---|
Images are not yet available
Images are not yet available